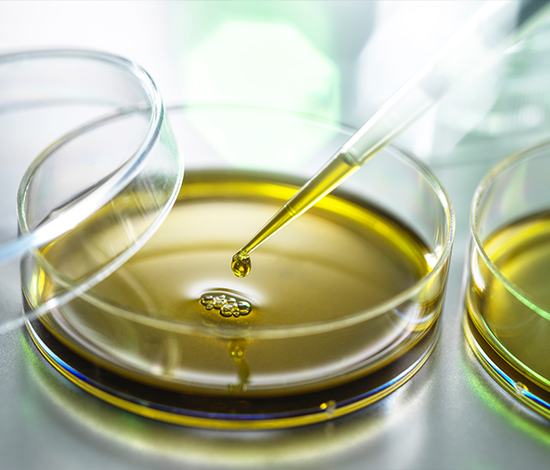

팝업레이어 알림
팝업레이어 알림이 없습니다.자연의 혁신, 인류의 건강
리뉴엘바이오는 연어 유래 성분 및 유해 어종을 활용하여
환경과 건강을 동시에 생각하는 바이오 솔루션을 제공합니다.
천연물로부터
그린바이오 소재 혁신을
선도하는 리뉴엘바이오입니다.
원료 공급 - 소재화 - 사료첨가제라는 자원순환 생태계를 구축하여
경쟁력 강화를 위한 지속적인 지식재산권 확보가 이루어지고 있습니다.
-

ESG 01
사료첨가제
-

ESG 02
원료공급
-

ESG 03
소재화



부산물의 고부가가치
바이오 소재화 및 상품화
Novel Protease 효소 기술로 차별화된 경쟁력을 보유하여,
지속 가능하고 환경친화적인 그린바이오 소재를 제공합니다.

STEP. 01 원료수급
MOU 협약 통한 안정적인 원료 수급

STEP. 02 이송
전용 용기 통한 원료 보관 & 이송

STEP. 03 유용성분 분리
자사 특허 Novel Protease 기반 저온 생물전환
STEP. 04 소재화
연어오일(EPA&DHA) 단백질 펩타이드, 칼슘제

Worldwide Export
리뉴엘바이노는 원료 추출 및 분리 독점 기술을 통해,
글로벌 시장 진출을 확대해 나갈것입니다.
-

Export Expansion
기확보된 협력사를 통한 동남아 및 남미 시장 수출
-

Feed Additive Extraction
연어오일, 단백질 펩타이트, 연어칼슘 추출
↑
TOP
TOP




